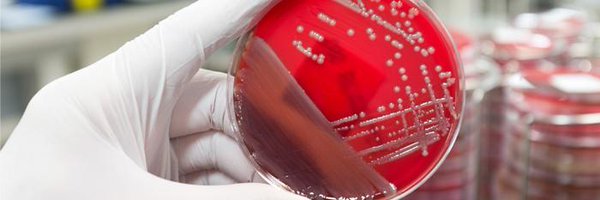
accpinfdprn Profile Banner

ACCP INFD PRN
@accpinfdprn
Followers
14K
Following
4K
Media
1K
Statuses
7K
American College of Clinical Pharmacy Infectious Diseases Practice and Research Network of nearly 2500 members. https://t.co/FgNX81Tp1b
#IDPRN
Joined November 2015
Great session on utility of bacteriophage therapy as adjunct to antibiotics for MDR infections from 2 ACCP members! While access is still limited to compassionate use only, phage therapy is a promising solution in the age of increasing AMR #ASHP25 #IDXPosts @ASHPOfficial
0
1
4
🚨Attending the ASHP Midyear Meeting this weekend? Meet up with other ID pharmacists at the SIDP & ACCP ID PRN social event on Sunday evening! Food and drink will be available for purchase. RSVP is encouraged ( https://t.co/Zv7fNFVQUT). See you there! #IDX
0
3
3
Just in time for Thanksgiving, @PaulSaxMD shares his list of 6 ID things he's grateful for in 2025: https://t.co/JNHc3tPIPp
#IDTwitter #GivingThanks
0
4
10
Have any of your facilities swapped from CrCl to eGFR-based dosing for renally adjusted antibiotics? 🧪💊 If so, what drove the change, and how has it impacted workflow, safety, or stewardship? Curious to hear what institutions are doing! #PharmacyTwitter #IDXposts #ACCP
0
0
7
☕️It's the weekend. Time to relax, unwind...and casually thumb thru some recent ID phase 3 clinical trials
0
2
2
#USAAW2025 ~9⃣0⃣% of abx are used outpatient—and ~3⃣0⃣% are inappropriate😲 Patient pressure is real, but communication skills (like DART🎯) ⬇️unnecessary prescribing Viral season is coming… what’s your outpatient AMS game plan? https://t.co/1RWQggogCn
https://t.co/2tx6cI3c3T
0
0
0
Antibiotics vs viruses = 0% target attainment🎯 Not even a loading dose will fix that💉 🦠🟣US Antibiotic Awareness Week: A reminder to choose the right tool🔧 #USAAW25 #antimicrobialresistance
https://t.co/wCeOv54DaG
0
3
13
"The problem of [antimicrobial resistance (#AMR)] has been seen as either not urgent or too difficult to solve. Neither is true." A Lancet Series spotlights this global issue & how existing infection prevention methods could save 750,000 lives a year: https://t.co/EMiEK9jFax
1
68
156
Bacterial STI prevention by DoxyPEP in men who have sex with men has raised concerns about antimicrobial drug resistance (AMR). This #USAAW25, read this @CIDJournal study on the impact of DoxyPEP on Neisseria gonorrhoeae AMR.
academic.oup.com
Postexposure doxycycline-based prophylaxis was associated with a significant increase in the frequency of Neisseria gonorrhoeae isolates with high-level re
1
9
18
It's #USAAW25! Join @CDCgov in going purple from Nov. 18-24. Wear purple and encourage local leaders and organizations to illuminate landmarks in purple. Together, we can combat #AntimicrobialResistance. Learn more: https://t.co/AfTIomeYcz
0
4
3
New #AASLD & #IDSA Hep B guidelines are out. 'To treat or not to treat'--that is still the question, now answered with refined criteria for treatment initiation, discontinuation, and special populations📚💊 https://t.co/emZAIqQeOf
0
2
3
Fighting #AntimicrobialResistance takes all of us. Education is key! #USAAW2025 kicks off with an opportunity to learn with experts from @cdcgov and @AZDHS. Join “Navigating the Fungal Landscape: Antifungal Stewardship in Action” | Nov. 19, 10:50 AM ET https://t.co/4Lu7BBUoo6
0
4
5
🦠It’s U.S. Antibiotic Awareness Week! ID pharmacists’ favorite holiday—because nothing brings joy like telling someone their antibiotic is unnecessary😌💊 Do your part: Wear PURPLE—it’s stewardship chic & hides grape jelly stains🍇 Spread awareness, not superbugs! #USAAW2025
0
1
4
🗓️ Mark your calendars for another exciting learner-led journal club! November 21 from 12-1 CT Check your email for the Zoom link! #IDxposts
0
0
4
Don’t worry if this week has been hectic - we’ve got you covered with these must-read papers 📖☕️ #ACCPIDPRN
0
6
11